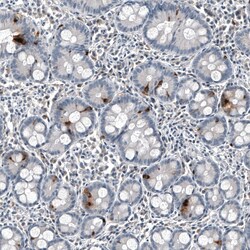
Chromogranin B Antibody (CL11404) - Azide and BSA Free, Novus Biologicals

missing translation for 'onlineSavingsMsg'
Learn More
Learn More
Chromogranin B Antibody (CL11404) - Azide and BSA Free, Novus Biologicals™
Mouse Monoclonal Antibody
Marke: Novus Biologicals NBP3-44183
Dieser Artikel kann nicht zurückgegeben werden.
Rückgaberichtlinie anzeigen
Beschreibung
Chromogranin B Monoclonal antibody specifically detects Chromogranin B in Human samples. It is validated for Immunohistochemistry (Paraffin),Immunocytochemistry/ Immunofluorescence,Immunohistochemistry
Spezifikation
| Chromogranin B | |
| Monoclonal | |
| LYOPH | |
| Immunocytochemistry/ Immunofluorescence 2-10 μg/mL, Immunohistochemistry-Paraffin 1:200 - 1:500 | |
| CgB, chromogranin B (secretogranin 1), Chromogranin-B, SCG1sgI, secretogranin B, Secretogranin I, secretogranin-1, SgI | |
| This antibody was generated using a recombinant protein sequence of P05060, with the exact immunogen sequence remaining proprietary. | |
| 100 μL | |
| Cell Biology, Cytokines and Growth Factors, Neuroscience, Signal Transduction | |
| 1114 | |
| Human | |
| Purified |
| Immunohistochemistry (Paraffin), Immunocytochemistry/Immunofluorescence, Immunohistochemistry | |
| CL11404 | |
| Unconjugated | |
| Lyophilized in 5% Trehalose. | |
| Mouse | |
| Protein A purified | |
| RUO | |
| Primary | |
| Centrifuge the vial of lyophilized antibody at 12,000 x g for 20 seconds. Reconstitute by adding sterile, distilled water to achieve a final antibody concentration of 1mg/mL. | |
| Store at 4⪚C short term. Aliquot and store at -20⪚C long term. Avoid freeze-thaw cycles. | |
| IgG1 |
Berichtigung von Produktinhalten
Bitte geben Sie uns Ihr Feedback zu den Produktinhalten, indem Sie das folgende Formular ausfüllen.
Name des Produkts
Haben Sie Verbesserungsvorschläge?Übermitteln Sie eine inhaltliche Korrektur